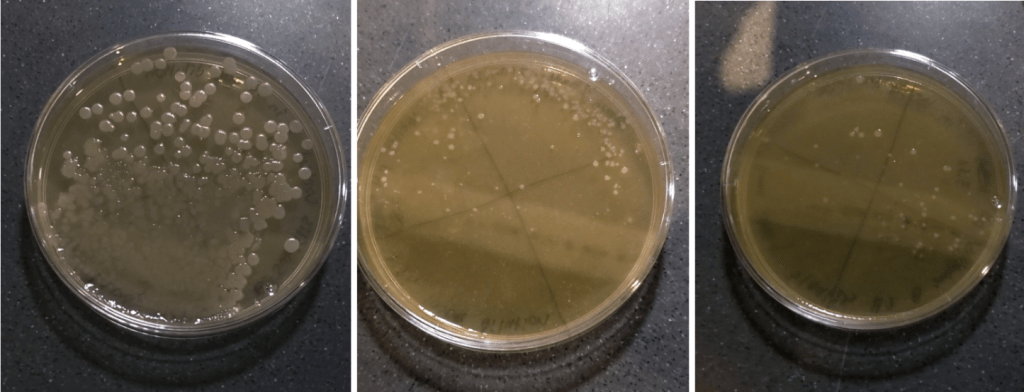
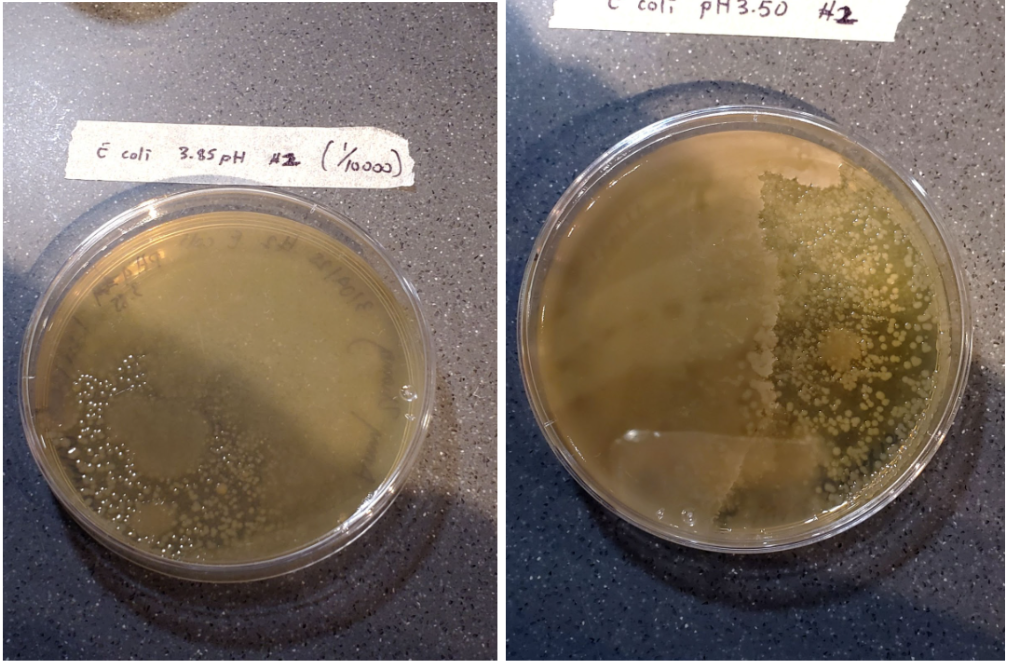

Amy Zhang – Life Science, Year 2
Abstract
B. subtilis is a potential candidate in sustainable agriculture through many aspects, such as crop resistance, biofilms, plant immunity, antifungal and antibiotic compounds, and nutrient conversion. B. subtilis especiallystands out in its tolerance to extreme environments as an extremophile, which could assist the agricultural industry through climate impacts. In this experiment, B. subtilis was tested for its’ ability to survive in acidic environments, and was compared to a mesophile – E. coli. Both B. subtilis and E. coli survived under the pH of 3.84 – 3.85, and 3.50 – 3.51. In the third trial, B. subtilis colonies survived at 5.78E+07 CFU/ml in the control group and 2.33E+07 CFU/mL in pH 3.51, respectively. In comparison, E. coli survived at 1.70E+08 CFU/ml in the control group and 4.70E+07 CFU/ml in the pH 3.51, respectively. This supports previous research that B. subtilis survives at a rate higher than mesophiles in acidic environments, and that B. subtilis may therefore be suitable to be used within microbial applications in agriculture.
Introduction
Climate change has affected our world in many aspects, including the sustainability of agriculture. In agriculture, it is becoming increasingly difficult to supply food (Velten et al., 2015). The agriculture industry has affected our world by driving climate change through the use of fossil fuels and harsh chemicals during deforestation, factory farming, and other practices. Therefore, agriculture faces the challenge of changing such practices to become a more sustainable industry (Velten et al., 2015). Amongst developing sustainable agriculture techniques is the application of beneficial microorganisms in agriculture. Within this application, a beneficial microorganism ideally thrives in various environments while improving crop growth through organic nourishment and disease prevention. Through previous research, scientists have identified microorganisms that fit such ideals, including Bacillus subtilis (Buzzotta, 2024).
B. subtilis is a well studied species of bacteria, with extensive knowledge accumulating over half a century (Harwood et al., 2013). B. subtilis has many unique capabilities that scientists have utilised. B. subtilis is capable of producing endospores resistant to extreme conditions, and it is known as an extremophile through exhibiting this trait. Horneck et al. (2010) have experimented with the capability of B. subtilis to survive extreme conditions through Apollo 16 and other laboratory simulation experiments. In another study, Horneck et al. (1993) tested B. subtilis for its survivability in different space parameters. The three SpaceLab experiments showed that B. subtilis spores (tested in monolayers without protection against dehydration) survived at a percentage of 47.0±9.4% to 69.3±15.8% in comparison to ground control experiment survival percents of 66.7±7.0 – 99.9±5.8 (Horneck et al., 1993). Through these experiments, B. subtilis demonstrates the extremophile trait necessary to support agriculture through climate change.
B. subtilis has already been used heavily in agriculture and fermentation. It inhabits soil, water, and plant rhizospheres and is capable of this because of its extremophile behaviour (Buzzotta, 2024). Not only can B. subtilis adapt to a variety of environments, but it is outstanding in its capability to colonize quickly, form biofilms, assist crop resistance, and compete against pathogens. (Buzzotta, 2024) These capabilities highlight the potential of B. subtilis to shift agricultural techniques. B. subtilis is able to compete against pathogens by occupying soil quickly, through its growth rate, allowing it to double every 20 minutes. (Buzzotta, 2024)
B. subtilis is beneficial to crop resistance, as it can form biofilms on plant roots, protecting crops against soil pathogens. (Buzzotta, 2024) This exposure to B. subtilis also increases the immunity of plants against diseases and pests through pathways like Systemic Acquired Resistance (SAR) and Induced Systemic Resistance (ISR). (Buzzotta, 2024) B. subtilis provides plants with the antifungal and antibiotic compounds it produces, which can be absorbed, protecting crops against harmful microorganisms. (Buzzotta, 2024). Not only is B. subtilis useful against pathogens, but it also benefits crops through nourishment. It can convert insoluble phosphates into a form that plants can take up through its secretion of organic acids and enzymes. Some strains of B. subtilis can convert nitrate into ammonia, nourishing plant growth similarly. B. subtilis has also been known to improve soil through the decomposition of organic matter. (Buzzotta, 2024)
These traits of B. subtilis sets it as a suitable microorganism in agriculture. Yet, the extent of the extreme environments that B. subtilis can tolerate is important, especially considering that B. subtilis must demonstrate strong tolerance to temperature, acidity, toxic metals, and other environmental factors that are affected by climate change, if it is to be used for agriculture in a changing world.
A study by Errington and Aart (2020) provided data that B. subtilis doubles at a rate of 20 mins at a temperature of 30°C to 35°C but can tolerate a temperature range of 25°C to 45°C. In a study by Sanjaya et al. (2022), B. subtilis growth at 25°C was 7.83 Log CFU/ml. At a much higher temperature of 40°C to 45°C, the B. subtilis growth was 8.27 Log CFU/ml and 8.24 Log CFU/ml, respectively. Another variable that Sanjaya et al. tested was the effect of pH on B. subtilis growth, showing it can grow under a pH range of 5-9, with optimal conditions at pH 8. The growth of B. subtilis for pH 7 and 8 are 8.13 ± 0.14 Log CFU/ml and 8.12 ± 0.01 Log CFU/ml, respectively. B. subtilis shows its tolerance to pH outside its optimal range with a growth of 7.56 ± 0.08 Log CFU/ml at pH 5 and 7.17 ± 0.06 Log CFU/ml at pH 9 (Sanjaya et al. 2022).
Another study by Sreedharan et al. (2024) observed the effect of different growth conditions on antimicrobial activity. Antimicrobial activity was tested through applying Escherichia coli 078:K80 (gram negative), Staphylococcus aureus (gram positive), and P. aeruginosa (gram negative) as indicators to determine the antimicrobial activity of B. subtilis through culture growth and a broth microdilution assay. The antimicrobial activity of B. subtilis increased as the pH values got higher, with the highest activity of 18.03% at a pH of 8. As the pH values decreased, so did the antimicrobial activity. At a pH of 4, the antimicrobial activity was 2.73%, a difference margin of 15.3% to the antimicrobial activity at a pH of 8 (Sreedharan et al., 2024).
B. subtilis demonstrates a strong tolerance to a variety of pH and temperature. Yet, to further understand the extremophile behaviour of B. subtilis, some studies compared B. subtilis against a non-extremophile bacteria, such as Escherichia coli.
Martinez II et al. (2012) published a study comparing the ability of E. coli and B. subtilis to regulate cytoplasmic pH. They found that E. coli biofilms failed to recover cytoplasmic pH through a switch in the perfusion medium from pH 7.5 to pH 5.5. In a shift from pH 7.5 to 6.0, although most of the E. coli biofilm recovered fully, the pH of isolated adherent cells took longer to recover (2 mins to 7 mins or longer). Yet, when B. subtilis cells were acid-shifted from pH 7.5 to 6.0, the cytoplasmic pH fell to a maintained level, even if it varied among individual B. subtilis cells (range of pH 7.0 to 7.7).
As E. coli and B. subtilis are neutralophilic (thriving at a pH around 6.5 to 7.5) and share similar tolerance to pH (Martinez et al., 2012), E. coli would be a suitable control to compare to B. subtilis when studying survivability. As B. subtilis can still have functional antimicrobial activity at pH 4-8, the range Martinez et al. tested may only be a small glimpse of the range of survivability of E. coli and B. subtilis.
For sustainable agriculture, further research is crucial to understand the ability of B. subtilis. It would be significant to test both B. subtilis at a wider pH range to further understand its survivability in acidic environments created by loss of biodiversity, soil pollution, and water pollution. (Velten et al., 2015) This study will aim to understand the survival rates of B. subtilis at a lower pH of 3.0 – 4.5. Providing more information about the survivability of B. subtilis in extreme pH conditions will enable further understanding and development toward sustainable agriculture.
Materials and Methods
Bacterial Culture
Two Petri dishes were prepared to grow both a B. subtilis culture and an E. coli culture. LB agar (Carolina) was put into each Petri dish. After the agar solidified, both B. subtilis and E. coli were transferred onto the Petri dish using a sterile inoculation loop, with the method of streak plating. Then the bacterial cultures were incubated for a week inside an incubator at 25°C.
Bacterial Suspension
Using a balance, 100ml of water and 0.9g of table salt were measured. The salt was then mixed into 100ml of water to create a saline solution of 0.9%. A 1 in 10 000 dilution was prepared through serial dilution for both B. subtilis and E. coli bacterial suspensions as stated below.
1.5ml of the saline solution was pipetted into a microcentrifuge tube. Three colonies of B. subtilis were transferred into a tube, through a sterile inoculation loop to create a stock suspension. Then, 100μL of the stock suspension was pipetted into a new tube containing 900μL of the saline solution to prepare a 1 in 10 dilution. Then 900μL of the saline solution was placed in all subsequent transformation reaction tubes for B. subtilis. After that, 100μL of the B. subtilis 1 in 10 dilution was placed into the transformation reaction tube labelled B. subtilis 1 in 100 dilution. This previous step was repeated up to the 1 in 10 000 dilution for B. subtilis. The serial dilution process was repeated for E. coli.
Experiment Methodology
The pH of 3.50 and the pH of 3.85 were prepared by diluting lemon juice in distilled water until the desired pH was achieved. These values were chosen to test the cultures at a lower acidity than previous experiments (a pH around 3.0 to 4.0). In the third trial, the lemon juice solutions had to be remade, and to collect similar data, a pH of 3.51 and 3.84 was prepared. During the third trial, the lemon juice concentration was reduced from 300μL to 150μL to increase visibility of the E. coli cultures.
Six Petri dishes were prepared. Three Petri dishes were for B. subtilis cultures, with a Petri dish as a control without any lemon juice, a Petri dish at pH 3.50, and a Petri dish at pH 3.85. The same was done for E. coli. These Petri dishes were labelled respectively and LB agar was put into each Petri dish. After the agar solidified, 300μL diluted lemon juice at pH 3.50 and pH 3.85 were put into the Petri dishes labelled pH 3.50 and pH 3.85 respectively. These Petri dishes were given ten minutes to soak in the diluted lemon juice. Then, using a micropipette, 160μL of B. subtilis and E. coli bacterial suspensions was transferred into plates labelled B. subtilis and E. coli respectively. Using a sterile plastic L spreader, the bacterial suspensions were immediately spread evenly across the agar. The Petri dishes rested for five minutes to ensure that the bacterial suspension soaked into the agar. Then, all six Petri dishes were put into the incubator at 25°C.
Results
Table 1 represents the CFU/ml values of B. subtilis as the average of three trials. B. subtilis produced an average of 3.28E+07 CFU/ml in the control group, an average of 1.73E+07 CFU/ml in pH 3.85, and an average of 2.16E+07 CFU/ml in pH 3.50. This shows that lower pHs produced a smaller CFU/ml value, indicating that fewer colonies survived at lower pH.
Table 1: CFU/ml of B. subtilis and E. coli were grown in different pH. For E. coli, CFU/ml values are from the third trial only, as there were uncountable colonies in the first and second trials. B. subtilis values are the average CFU/ml from all three trials.
Figure 1: Mean CFU/ml for B. subtilis grown in control, pH 3.85, and pH 3.50 treatment groups.
Figure 2 represents the CFU/ml values of E. coli from the third trial. E. coli produced 1.70E+08 colonies in the control group, 1.16E+08 colonies in pH 3.85, and 4.70E+07 colonies in pH 3.50.
Figure 2: E. coli CFU/ml for control, pH 3.85, and pH 3.50 treatment groups in Trial 3.
Figure 3 represents B. subtilis CFU/ml values from the third trial. In this table, the pH 3.50 group grew 4.08E+07 CFU/ml, a higher value in comparison to the pH 3.85 group, which grew 2.33E+07 CFU/ml. This trial differs from the previous two trials in this aspect, yet this trial still supports the hypothesis that B. subtilis grows colonies at lower pHs.
Figure 3: B. subtilis CFU/ml from the third trial
Qualitative Data
These are the B. subtilis colonies in the first trial of the experiment. Figure 4 shows the reduction in the diameter sizes of the colonies. Although it is qualitative data, it is noticeable that the colony’s diameter reduces as the pH decreases.
Figure 4: (a) B. subtilis in control (b) B. subtilis at pH 3.8 (c) B. subtilis at pH 3.50
Figure 5 shows the uncountable E. coli colonies from the second trial at pH of 3.85 and 3.50. There are areas where it is difficult to distinguish colonies and to produce a CFU/ml value.
Figure 5: (a) E. coli at pH 3.85 (b) E. coli at pH 3.50
Figure 6 shows countable E. Coli colonies from the third trial.
Figure 6: (a) E. coli in the control (b) E. coli at pH 3.84 (c) E. coli at pH 3.51
Discussion
Within previous experiments, such as the study conducted by Martinez et al. (2012), both B. subtilis and E. coli were tested at a pH range of 5.5 to 8.5, illustrating their tolerance at acidic and basic pHs. In this experiment, B. subtilis and E. coli were experimented at a lower range of pH 3.50 to 3.85.
In each trial, even though there were fewer colonies (in comparison to the control group) in plates of pH 3.50 and 3.85, B. subtilis were able to grow in acidic plates. In the first trial, it is notable that the diameters of B. subtilis colonies reduced as the acidity increased in the plates as shown by Figure 4. In the third trial, the lemon juice concentration was reduced. This was due to uncountable E. coli cultures in the first and second trials (Figure 5), resulting potentially due to residual lemon juice preventing separate colony growth. Therefore, in the third trial, a reduced volume of lemon juice produced countable colonies on the E. coli (Figure 6).
This data indicates that B. subtilis can survive and produce colonies in acidic environments at higher rates, compared to a mesophile E. coli (Kumar P. & Libchaber A., 2013), which supports previous data such as the studies conducted by Martinez et al. (2012), Sanjaya et al. (2022), and Sreedharan et al. (2024), stating that B. subtilis adapts to acidic environments better than E. coli, showing its potential as a microorganism to utilize in agriculture.
A limitation of this project is that a McFarland standard was unable to be used to standardize the number of bacteria in a liquid suspension. This allows for the number of colonies on the Petri dishes to differ, creating variables when comparing the B. subtilis Petri dishes and the E. coli Petri dishes.
Another limitation of this project is the variation created by slight differences in timing, such as the time each Petri dish soaked in the lemon juice differed, and the time the bacterial suspension soaked into each Petri dish also differed. The variations created may have affected the growth of the colonies and thus the data used should be considered with this possible confounding variable in mind. In the third trial, the plate with a pH of 3.51 had 4.08E+07 CFU/ml in comparison to the plate at a pH of 3.85 with 2.33E+07 CFU/ml (Table 3). This trial’s trend may be caused by the variation previously stated.
Within previous experiments, such as the study conducted by Martinez et al. (2012), both B. subtilis and E. coli were tested at a pH range of 5.5 to 8.5, illustrating their tolerance at acidic and basic pHs. Within this experiment, both E. coli and B. subtilis survived within pHs of 3.85 and 3.50. Although this experiment collects data about the growth of both B. subtilis and E. coli at an acidic pH, further repetition with this experiment should be done. Furthermore, more experimentation should be conducted to test the tolerance of both E. coli and B. subtilis in highly basic (pH 10 or above) as it can be informative to understand the most acidic and basic environments that E. coli and B. subtilis can endure, and what pH range B. subtilis and E. coli are capable of surviving in. As pollution from unsustainable practices has produced acidic and alkaline soils (Gomes et al., 2015), it is crucial to measure microbial tolerance to pH, amongst other factors, to understand its capabilities. Other factors that test both the tolerance of E. coli and B. subtilis in their environments, such as temperature, radiation, heavy metals, and more, should also be explored. This research is crucial, as applications of microbes in agriculture may provide us with a sustainable and efficient way to sustain our globe while combating climate change.
References
Buzzotta, L. (2024). The natural dynamo sustainably unlocking soil and crops potential: Bacillus subtilis. Illuminem. https://illuminem.com/illuminemvoices/the-natural-dynamo-sustainably-unlocking-soil-and-crops-potential-bacillus-subtilis
Errington, J., & Aart, L. T. van der. (2020). Microbe profile: Bacillus subtilis: Model organism for cellular development, and Industrial Workhorse. Microbiology (Reading, England). https://pmc.ncbi.nlm.nih.gov/articles/PMC7376258/
Gomes, H. I., Mayes, W. M., Rogerson, M., Stewart, D. I., & Burke, I. T. (2015). Alkaline residues and the environment: A review of impacts, management practices and opportunities. Journal of Cleaner Production, 112, 3571-3582. https://www.sciencedirect.com/science/article/pii/S0959652615013396#sec3
Harwood, C. R., Pohl, S., & Wipat, A. (2013). Bacillus subtilis: Model gram-positive synthetic biology chassis. Methods in Microbiology. https://www.sciencedirect.com/science/article/abs/pii/B9780124170292000042
Horneck, G. (1993). Responses of Bacillus subtilis spores to space environment: Results from experiments in Space. Origins of life and evolution of the biosphere : the journal of the International Society for the Study of the Origin of Life. https://pubmed.ncbi.nlm.nih.gov/8433836/
Horneck, G., Bucker, H., & Reitz, G. (1994). Long-term survival of bacterial spores in space. Advances in space research : the official journal of the Committee on Space Research (COSPAR). https://pubmed.ncbi.nlm.nih.gov/11539977/
Horneck, G., Klaus, D. M., & Mancinelli, R. L. (2010). Space microbiology. Microbiology and molecular biology reviews : MMBR. https://pubmed.ncbi.nlm.nih.gov/20197502/
Kumar, P., & Libchaber, A. (2013). Pressure and temperature dependence of growth and morphology of Escherichia coli: experiments and stochastic model. Biophysical journal, 105(3), 783–793. https://doi.org/10.1016/j.bpj.2013.06.029
Martinez, K. A., 2nd, Kitko, R. D., Mershon, J. P., Adcox, H. E., Malek, K. A., Berkmen, M. B., & Slonczewski, J. L. (2012). Cytoplasmic pH response to acid stress in individual cells of Escherichia coli and Bacillus subtilis observed by fluorescence ratio imaging microscopy. Applied and environmental microbiology, 78(10), 3706–3714. https://doi.org/10.1128/AEM.00354-12
Sanjaya, A. P., Praseptiangga, D., Zaman, M. Z., Umiati, V. F., & Baraja, S. I. (2023, June). Effect of pH, temperature, and salt concentration on the growth of Bacillus subtilis T9-05 isolated from fish sauce. In IOP Conference Series: Earth and Environmental Science (Vol. 1200, No. 1, p. 012050). IOP Publishing. https://iopscience.iop.org/article/10.1088/1755-1315/1200/1/012050
Schallmey, M., Singh, A., & Ward, O. P. (2004). Developments in the use of Bacillus species for industrial production. Canadian journal of microbiology. https://pubmed.ncbi.nlm.nih.gov/15052317/
Sreedharan, D. K., Alias, H., Makhtar, M. M. Z., Shun, T. J., Mokhtar, A. M. A., Shukor, H., Siddiqui, M. R., Alam, M., Kapoor, R. T., & Rafatullah, M. (2024, January 24). Screening of different growth conditions of Bacillus subtilis isolated from membrane-less microbial fuel cell toward antimicrobial activity profiling. Open life sciences, 19(1), 20220809. https://pmc.ncbi.nlm.nih.gov/articles/PMC10811530/
Tankeshwar, A. (2023). Psychrophiles, mesophiles, thermophiles. Microbe Online. https://microbeonline.com/psychrophiles-mesophiles-thermophiles/
U.S. Environmental Protection Agency. (1997). Final risk assessment of Bacillus subtilis. Attachment I — Final Risk Assessment OF Bacillus subtilis. https://www.epa.gov/sites/default/files/2015-09/documents/fra009.pdf
Velten, S., Leventon, J., Jager, N., & Newig, J. (2015). What Is Sustainable Agriculture? A Systematic Review. Sustainability, 7(6), 7833-7865. https://doi.org/10.3390/su7067833